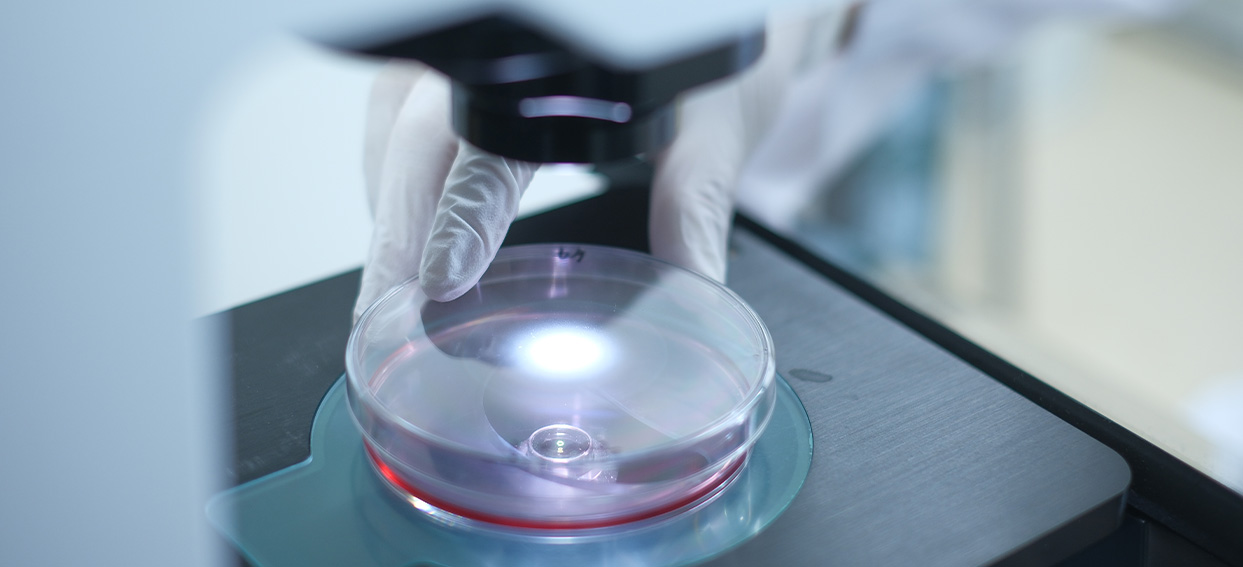
イメージ:共同利用・共同研究拠点 PRiME

Message from the Director
Proteins are the fundamental building blocks of life. Proteins in higher organisms, including humans, rarely function on their own, but work in complexes with other proteins. Therefore, in addition to elucidating the functions of individual proteins, the elucidation of protein complex networks (proteo-interactomics) is of fundamental importance in life science research.
PRiME studies protein complexes, which are often composed of multiple types of proteins, as functional units, rather than proteins that function on their own. This concept was born from the need to deepen our understanding of biological phenomena involving protein complexes in order to seek new targets for drug discovery. PRiME provides both biochemical interactome analyses using protein arrays (our speciality!), and in vivo interactome analyses using proximal-dependent biotinylindole (AirID), to researchers in all fields of life sciences. We hope to stimulate a wide range of basic life science research fields through the promotion of collaboration. We hope that this will lead to a better understanding of basic life science mechanisms, but also to the identification of drug and vaccine targets. We are looking forward to collaborating with you all!
PROS Joint Research Program for Protein Interactome (PRiME), Ehime University
Director Tatsuya Sawasaki, PhD